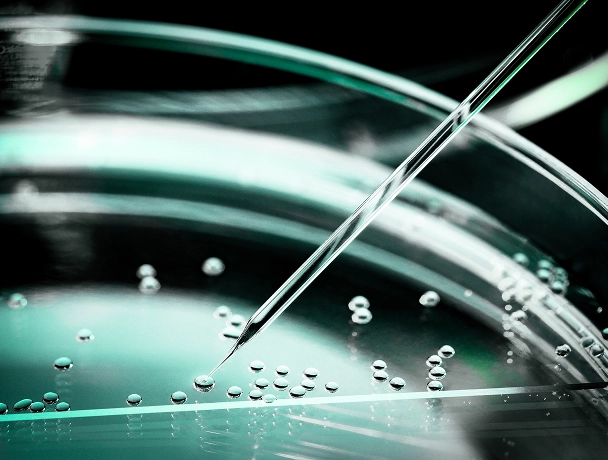

Follistatin Gene Therapy at GARM Clinic
Follistatin gene therapy is a cutting-edge regenerative treatment that uses your body’s own cellular machinery to boost muscle growth, enhance metabolic health, and potentially slow the effects of aging.
Follistatin - A Naturally Occurring Protien
This therapy works by increasing the levels of follistatin—a naturally occurring protein that blocks myostatin and other growth inhibitors—unlocking your body’s ability to build lean muscle and improve strength, stamina, and recovery.
At GARM Clinic, we’re proud to be the original, exclusive provider of Minicircle’s plasmid-based follistatin gene therapy, available to patients since 2022. We offer this innovative treatment to individuals seeking a safe, non-permanent gene therapy option designed to optimize physical performance, combat age-related muscle loss, and support long-term vitality.
Whether you're experiencing muscle decline, exploring preventive aging strategies, or simply want to feel stronger and more resilient, follistatin therapy at GARM Clinic may help you unlock a higher level of health.
How Follistatin Works in the Human Body
Gene therapy can sound complex, but at its core, this treatment is about helping your body do something it already knows how to do—build and maintain strong, healthy muscle. Follistatin is the molecular key that makes this happen.
What is Follistatin?
Follistatin is a protein your body naturally produces in small amounts, primarily in muscle tissue, the liver, and reproductive organs. Its main job? To block certain signaling molecules that limit tissue growth—especially in muscles.
Think of follistatin as your body’s internal “growth liberator.” By binding to and neutralizing proteins like myostatin and activin A, it removes the biological brakes that slow down muscle development and regeneration.
The specific version used in gene therapy—Follistatin 344—is a form optimized for circulation in the bloodstream. That means it doesn’t just stay in one place; it has the potential to impact multiple muscle groups and even support systemic benefits.
Myostatin, Activin, and the Muscle Growth Switch
Your muscles don’t grow by accident. They’re tightly regulated by a balance of signals telling them when to grow, when to stay the same, and when to slow down.
Two of the most powerful “stop” signals in this system are:
• Myostatin (also called GDF-8): Tells your body to limit muscle size. High levels = smaller, weaker muscles.
• Activin A: A multitasker protein involved in inflammation, hormonal regulation, and also muscle inhibition.
Follistatin flips the switch by binding to both of these and shutting down their ability to send “stop” signals. The result? Your body becomes primed to:
• Grow new muscle fibers
• Increase the size of existing fibers
• Reduce scar tissue (fibrosis) in damaged muscle
• Improve repair and regeneration speed
How Plasmid-Based Gene Therapy Delivers Follistatin
Traditional supplements can’t deliver follistatin directly—it would break down in your stomach. That’s why gene therapy is the only effective method to raise follistatin levels in a meaningful, lasting way.
At GARM Clinic, we use a non-viral, plasmid-based gene therapy to trigger your cells to make their own follistatin.
Here’s how it works:
You receive a simple subcutaneous injection containing a minicircle plasmid—a circular piece of DNA carrying the human FST gene.
A delivery enhancer (like polyethyleneimine) helps your cells absorb the plasmid.
Once inside your cells, the plasmid acts like a temporary instruction manual—telling your cells to produce follistatin 344 for weeks to months.
This increased production boosts your circulating follistatin levels naturally, without altering your DNA.
The result? Your body makes more of its own muscle-supporting protein, without the need for drugs, hormones, or risky synthetic compounds.
Plasmid vs. Viral Gene Therapy: What’s the Difference?
Most people have heard of viral gene therapy—where a virus is used as a delivery vehicle to insert new genes. While powerful, that approach is permanent, expensive, and can carry higher risks, especially for healthy individuals.
Plasmid gene therapy is different. It’s:
Feature
Integration into DNA
Safety Profile
Regulatory Oversight
Ideal Use Case
Repeatable?
Plasmid Therapy (Used at GARM)
No (temporary expression only)
Very high
Fewer barriers in innovation zones
Longevity, wellness, performance
Yes – can be administered again safely
Viral Gene Therapy
Yes (permanent insertion possible)
Higher immune/inflammatory risk
Heavily restricted globally
Rare, severe genetic diseases
No – immune response may prevent repeat use
By using a plasmid instead of a virus, GARM Clinic is able to offer a customizable gene therapy that fits the needs of proactive adults—not just those with life-threatening genetic conditions.
Benefits of Follistatin Gene Therapy
Follistatin gene therapy is not just about adding muscle—it's about unlocking a cascade of physiological upgrades that can transform the way your body feels, functions, and ages. By raising your follistatin levels, this therapy works upstream, triggering improvements that ripple across multiple systems.
This is the most immediate and well-documented benefit.
Follistatin suppresses myostatin, the protein that tells your body to stop building muscle. When that signal is removed, your muscle fibers are free to grow larger and stronger—often beyond what’s possible through exercise alone.
Patients typically experience:
• Noticeable increases in lean muscle mass (up to 2–10+ pounds in early trials)
• Enhanced response to resistance training
• Faster recovery from workouts and injuries
• A more defined, athletic appearance
Unlike anabolic steroids or SARMs, this growth is endogenous—your own body doing the work.
When you gain muscle, you burn more calories at rest. But follistatin gene therapy may do even more than that.
Emerging evidence suggests it also:
• Promotes visceral fat reduction (the deep belly fat tied to chronic disease)
• Improves fat distribution (lower waist-to-hip ratios)
• Triggers “browning” of fat—turning energy-storing white fat into energy-burning beige fat
The result is body recomposition: more muscle, less fat, without necessarily losing scale weight.
This isn’t just about aesthetics. Stronger muscles directly translate to better real-world function.
Patients report:
• Greater stability and balance
• Increased walking endurance and stair-climbing ability
• More vitality during workouts and daily tasks
• Reduced fatigue and burnout
For older adults or those with early signs of frailty, this can be life changing. For high performers, it means more output with less wear and tear.
Follistatin interacts with more than just muscle—it also binds to activin A, which influences hormones, inflammation, and metabolism.
That opens the door to powerful downstream effects, including:
• Improved insulin sensitivity
• Lower inflammatory markers (like CRP and homocysteine)
• Better lipid profiles in many patients (though some experience mild LDL shifts)
• Potential support for hormonal balance (via modulation of FSH signaling)
While not a substitute for lifestyle changes, follistatin therapy creates a metabolic environment that supports health—especially valuable for patients battling age-related metabolic slowdown.
Perhaps the most exciting frontier: cellular rejuvenation.
In a landmark 2024 trial, participants showed:
• Up to 7+ years reversal in epigenetic (biological) age
• Modest telomere lengthening
• Improvements in biomarkers associated with longevity
What does that mean for you?
More than looking younger—it’s about extending healthspan: the number of years you feel strong, independent, and resilient.
Follistatin gene therapy isn’t a silver bullet, but when combined with good nutrition, movement, and recovery, it could be a cornerstone of serious longevity protocols.
What does that mean for you?
More than looking younger—it’s about extending healthspan: the number of years you feel strong, independent, and resilient.
Follistatin gene therapy isn’t a silver bullet, but when combined with good nutrition, movement, and recovery, it could be a cornerstone of serious longevity protocols.
Who Is This Therapy For?
Follistatin gene therapy isn’t just for one type of person. It’s a breakthrough with broad potential—from older adults seeking to reverse frailty to high performers looking to push their physical limits. That said, not everyone is a fit. Below is a breakdown of who this therapy is best suited for—and who should steer clear.
If any of the following describe you, you may be an excellent candidate for follistatin gene therapy:
Age 35–80
Patients should be 35-80 years of age.
Muscle Decline
Experiencing age-related muscle decline or weakness
Muscle Loss
Recovering from muscle loss due to illness, injury, or immobility
Health Improvements
Looking to improve strength, stamina, and metabolic health
Healthspan Extension
Interested in regenerative medicine and healthspan extension
No Major Contraindications
Cleared of major contraindications (see below)
Every patient at GARM Clinic is medically screened for safety and suitability before beginning therapy.
Follistatin Gene Therapy is for:
One of the fastest-growing uses of follistatin therapy is in preventive aging protocols.
This therapy may be appropriate for:
• Adults in their 40s–60s noticing early signs of muscle loss, fatigue, or body recomposition challenges
• Healthspan-focused individuals seeking to prevent frailty and metabolic decline
• People already investing in longevity optimization via hormone therapy, peptides, or NAD+
For these patients, follistatin therapy becomes a cornerstone tool to maintain youthful muscle tone, strength, and metabolic flexibility well into their later decades.
Follistatin therapy has shown strong results in patients with:
• Sarcopenia (age-related muscle atrophy)
• Inclusion body myositis or Becker muscular dystrophy (based on early clinical trials)
• Post-ICU or post-surgical atrophy
• Chronic disuse or sedentary deterioration
In these cases, it acts as a regenerative catalyst—helping rebuild muscle where conventional rehab alone may fall short.
It is not a cure for neuromuscular diseases, but it can support strength, mobility, and independence as part of a broader care plan.
For healthy adults, follistatin gene therapy offers a next-level tool for:
• Accelerating muscle development beyond normal plateaus
• Enhancing recovery from high-volume or high-intensity training
• Supporting a leaner, more muscular physique with less fat gain during bulking cycles
Important note: While this therapy is often sought by athletes, it is prohibited by WADA and most professional sports leagues. If you are a competitive athlete, this treatment could disqualify you from sanctioned competition.
For recreational fitness enthusiasts, however, it can be a safe, effective performance enhancer when paired with structured training and nutrition.
Who Should Not Receive Follistatin Gene Therapy?
Follistatin therapy is not recommended for individuals with:
Active cancer
Active cancer or high cancer risk
Uncontrolled chronic illness
(e.g., severe heart disease, advanced diabetes)
Autoimmune disorders
Autoimmune disorders or on immunosuppressive medications
Pregnancy
Pregnancy or plans to conceive soon
Under age 18
Patients need to be above 18
Follow-up monitoring
Inability to comply with follow-up monitoring
It’s also not suitable for patients with unrealistic expectations or those seeking overnight transformations without lifestyle effort.
At GARM Clinic, every patient undergoes thorough screening to ensure the benefits outweigh any potential risks.
Clinical Evidence and Human Trials
Follistatin gene therapy isn’t just theoretical—it’s been studied in real people, under real-world and clinical trial conditions. While the field is still emerging, the early data is promising, particularly in muscle-wasting conditions and aging-related muscle loss. Below is a breakdown of the key findings to date, including peer-reviewed studies and GARM Clinic’s own treatment data.
Published Trials and Peer-Reviewed Research
The foundation of this therapy lies in decades of myostatin inhibition research and targeted gene delivery studies. Key findings include:
• McPherron et al. (1997): Showed that myostatin knockout mice developed nearly double the normal muscle mass, establishing myostatin as a brake on muscle growth.
• Lee & McPherron (2001): Demonstrated that follistatin overexpression in mice could suppress both myostatin and activin, resulting in even greater muscle growth than myostatin inhibition alone.
• Nakamura et al. (2009): Validated that the Follistatin 344 isoform is ideal for systemic circulation and therapeutic gene transfer.
• Rossi et al. (2011, Molecular Therapy): Found AAV1-FS344 gene therapy to be safe and tolerable in preclinical models, laying the groundwork for human trials.
These studies established that follistatin is a potent, upstream regulator of muscle development—and that safe delivery into humans was feasible using modern gene therapy platforms.
Results in Muscle Disorders (e.g., BMD, IBM)
Becker Muscular Dystrophy (BMD):
A Phase 1/2a trial conducted by Mendell et al. at Nationwide Children’s Hospital delivered AAV1-FS344 into the quadriceps of patients with BMD.
✅ All participants showed functional improvements, including:
• Increased distance in 6-minute walk tests
• Faster stair climbing
• Larger muscle fibers on biopsy and reduced fibrosis
Inclusion Body Myositis (IBM):
In a separate trial, patients with IBM received the same therapy into both thighs. After one year:
✅ Treated patients gained an average of 56 meters in walking capacity, while control patients declined by 26 meters (p = 0.01)
✅ Muscle biopsies confirmed fiber regeneration and less scar tissue
These studies were published in Molecular Therapy and remain the most robust clinical evidence for follistatin gene therapy in degenerative muscle diseases.
Sources:
• Mendell et al., Molecular Therapy, 2015
• Mendell et al., Molecular Therapy, 2017
Human Trials for Aging and Performance
In 2024, Minicircle conducted a groundbreaking Phase 1 trial using plasmid-based follistatin therapy in 43 healthy adults aged 23–88.
Each subject received a single subcutaneous injection of a Minicircle plasmid carrying FST344, paired with a PEI delivery enhancer.
Key outcomes (3-month follow-up):
• Average lean muscle gain: 1.96 lbs
• Average fat loss: 0.87% body fat
• Up to 12.15 lbs of muscle gained in top responders
• Decreases in CRP and homocysteine (inflammation markers)
• Average epigenetic age reversal: 7.1 years
• No serious adverse events reported
These results suggest potential for both physical and cellular rejuvenation. Importantly, the therapy was well-tolerated across all age groups, including seniors.
Source: Minicircle Follistatin Gene Therapy Trial (2024), publicly presented summary data
Observational Data from Clinics Like GARM
As the exclusive provider of Minicircle gene therapy in the Americas, GARM Clinic has been administering follistatin gene therapy to patients since 2022. While formal clinical trial data is still being compiled, internal patient tracking has shown:
• Significant gains in strength and endurance in patients over 50
• Improved recovery times from training or injury
• Body composition improvements (more lean mass, less visceral fat)
• No serious complications or adverse events in monitored patients
• Strong compliance with follow-up testing and positive subjective outcomes
GARM’s medical team monitors key biomarkers and patient-reported metrics throughout the post-treatment process. Our ongoing contribution to the data pool is shaping the next generation of regenerative medicine protocols for aging and performance.
Is Follistatin Gene Therapy Safe?
Safety is a top priority for any medical intervention—especially when the word “gene” is involved. Fortunately, follistatin gene therapy, particularly the plasmid-based approach used at GARM Clinic, has demonstrated a strong safety profile in early trials and real-world use. This section covers what you need to know about risks, safeguards, and how this therapy compares to other genetic treatments.
Known Risks and Monitoring
No therapy is entirely risk-free, but the known side effects of follistatin gene therapy have been minimal and manageable in published trials and clinical practice.
Reported side effects (rare and typically mild)
• Temporary injection site swelling or soreness
• Mild flu-like symptoms (fatigue, low-grade fever, muscle aches)
• Occasional transient increases in LDL cholesterol (requires monitoring)
What has not been reported
• No organ damage
• No autoimmune reactions
• No serious adverse events in any peer-reviewed or published trial to date
All patients at GARM Clinic are monitored for
• Inflammatory markers (e.g., CRP, homocysteine)
• Hormonal levels and lipid panels
• Liver and kidney function
• Lean mass and fat distribution via DEXA or similar scanning
If any red flags appear, follow-up plans are put in place immediately.
Temporary vs Permanent Gene Expression
One of the most important distinctions with the plasmid-based approach (used at GARM) is that it is non-integrating.
In plain terms:
❌ It does not permanently alter your DNA
✅ It does temporarily provide your cells with instructions to make follistatin
⏳ Expression typically lasts 6–12 months, depending on individual biology
This makes the treatment:
Repeatable (patients may return for a new dose once effects taper)
Ideal for proactive adults who want flexibility in their longevity plan
In contrast, viral vector therapies—while useful for genetic diseases—permanently integrate into your genome and may carry higher long-term risks. That’s why GARM intentionally chose the plasmid model for its superior safety in elective applications.


Screening and Pre-Treatment Process
Before beginning therapy, every patient undergoes a comprehensive medical screening to determine suitability and minimize any risk.
Screening includes:
• Full medical history review
• Recent lab panels (metabolic, liver, kidney, cardiovascular, inflammation)
• Pregnancy testing (where applicable)
• Imaging (optional but recommended for baseline body composition)
• Fitness-for-treatment clearance
If any red flags appear—such as active cancer, uncontrolled chronic illness, or autoimmunity—the patient will be advised not to proceed or referred for further evaluation.
This isn’t just protocol. It’s how GARM ensures that only well-matched, low-risk patients receive gene therapy, preserving safety and outcomes.
GARM’s Oversight and Clinical Protocols
GARM Clinic operates in a regulated medical innovation zone where emerging therapies can be administered with proper oversight, ethics review, and documentation.
What that means for patients:
• Your therapy is delivered under licensed physician supervision
• The plasmids used are sourced from GMP-compliant facilities
• Your response is tracked through follow-up testing and communication
• Adverse event reporting and safety auditing are part of the process
GARM also participates in longitudinal data collection to contribute to ongoing research, ensuring that safety data continues to grow over time.

Bottom Line
You’re not just getting access to cutting-edge therapy—you’re getting it in an environment built for rigor, transparency, and patient-first care.
Schedule a ConsultationTreatment Process at GARM Clinic
From your first inquiry to your final follow-up, GARM Clinic delivers a patient experience that is structured, supportive, and medically world-class. Our clinic—located in the innovation-friendly jurisdiction of Roatán, Honduras—is one of the only places on Earth where you can receive legally administered, physician-guided follistatin gene therapy today.
Your treatment journey at GARM is designed to be clear, efficient, and personalized. Here’s what the full process looks like:
Application & Intake
• Submit a simple online interest form
• A GARM care coordinator will contact you within 24–48 hours
• You’ll complete a medical questionnaire + lab work to assess eligibility
Physician Review
• Your case is reviewed by our clinical team
• Consultation with physician
• If you’re approved, we’ll schedule your visit and guide you through logistics
Treatment Day
• You’ll receive a single subcutaneous injection of the plasmid-based follistatin gene therapy
• The procedure takes under 30 minutes and requires no anesthesia or downtime
Post-Treatment Monitoring
• You’ll undergo optional but recommended follow-up testing after you leave (e.g., DEXA, labs)
• Follow-up occurs remotely at 1, 3, 6, 9, 12, 18, and 24 months to track response and outcomes
The total trip typically spans 3–5 days, giving you time to rest, enjoy the island, and begin recovery with full support.
Travel and Preparation for Treatment
Location: GARM Clinic is located in Roatán, Honduras, a Caribbean island with a U.S.-friendly medical innovation framework and direct flights from many U.S. cities.
What’s included:
• Airport pickup and private transportation
• Hotel recommendations and booking support
• Local concierge team to assist during your stay
• Clinic visits scheduled around your travel itinerary
Pre-trip checklist:
• Submit required labs and forms at least 2 weeks prior to your scheduled visit
• Avoid NSAIDs and alcohol 72 hours before treatment (if advised)
• Plan for light activity post-injection, not intense exercise
Travelers often combine their visit with a relaxing retreat, fitness getaway, or a full regenerative medicine package.
Post-Treatment Follow-Up and Optimization
Follistatin expression typically begins within 7–14 days post-treatment and may peak around weeks 4–8.You’ll receive:
• Personalized lab tracking recommendations (e.g., muscle enzymes, inflammatory markers, DEXA scans)
• Coaching on nutrition, recovery, and resistance training to amplify results
• Ongoing support via email or video consults with the GARM medical team
Many patients experience improved strength, composition, or energy within the first 1–2 months. Some return for re-administration after 9–12 months if desired.
Pricing and Availability
Out of pocket
As of 2025, GARM Clinic offers follistatin gene therapy as an elective and out of pocket procedure to patients traveling to Roatan.
Insurance Coverage
This therapy is not covered by insurance, but may be eligible for HSA/FSA or medical tourism financing in some cases. Packages can be combined with other regenerative therapies (e.g., NAD+, stem cell procedures, functional medicine consults) for a comprehensive protocol.
Limited Availability
Due to high demand and limited supply of gene-grade plasmids, we accept a limited number of patients each month.
The Science Behind Plasmid Gene Therapy
Follistatin therapy at GARM Clinic uses a plasmid-based, non-viral gene delivery system—a safe and innovative approach to temporarily upregulate follistatin in your own cells. Unlike traditional gene therapies that permanently alter DNA using viruses, plasmid therapy uses recombinant DNA in a circular format to create short-term, high-impact biological change.
What Is a Plasmid?
A plasmid is a small, circular piece of DNA. In nature, bacteria use plasmids to share information like antibiotic resistance. In medicine, we use them as vehicles to deliver therapeutic genes into human cells.
Plasmids act like a short-term instruction manual. Once inside your cells, they tell your cellular machinery to produce a specific protein—in this case, human follistatin 344.
Key advantages:
• Non-integrating: Doesn’t alter your permanent DNA
• Transient: Expression typically lasts 6–12 months
• Safe: No use of viruses, reducing immunogenic risk


Recombinant DNA and Therapeutic Gene Insertion
The term recombinant DNA simply means DNA that has been artificially engineered. In this therapy, the FST gene (which encodes follistatin 344) is inserted into a plasmid backbone using laboratory techniques.
Here’s how it works:
1. Scientists isolate the exact gene sequence for human follistatin 344.
2. That sequence is inserted into a circular DNA plasmid using restriction enzymes and ligase (think “molecular scissors and glue”).
3. The resulting plasmid is grown in bacteria, purified, and made injection-ready.
4. When injected into the body, the plasmid enters host cells, where it’s transcribed and translated like any other piece of cellular DNA.
5. Your cells then begin to produce the follistatin protein, boosting your levels naturally.
This is a non-permanent form of gene activation—you’re not editing the genome, just temporarily giving your cells new instructions.
Minicircle Technology Overview
At GARM, we don’t use standard plasmids—we use minicircle plasmids, an advanced subclass that increases expression while reducing risk.
Here’s what sets them apart:
Feature
Integration into DNA
Safety Profile
Regulatory Oversight
Ideal Use Case
Repeatable?
Standard Plasmid
4,000–10,000+ base pairs
Yes
Moderate
Weeks–months
Safe
Minicircle Plasmid (Used at GARM)
<2,000 base pairs
No
High
Months–12+ months
Ultra-safe (no bacterial remnants)
Minicircles remove non-essential genetic “junk” like antibiotic resistance markers or bacterial promoters, leaving only the therapeutic gene and a minimal promoter. That makes them:
• Easier for the body to tolerate
• More efficient in protein production
• Less likely to cause immune reactivity or inflammation
This is the cleanest gene delivery system available today, and it's one of the reasons GARM’s approach is so well-tolerated—even in older or health-conscious patients.
How It Compares to Other Gene Therapies
Let’s break it down clearly:
Comparison Area
Mechanism
DNA Integration
Ideal Use Case
Immunogenicity
Repeatability
Regulatory Flexibility
Plasmid (Minicircle)
DNA delivered in plasmid form
❌ No (temporary expression only)
Longevity, fitness, anti-aging
🟢 Low risk
✅ Can repeat doses safely
Available in innovation zones
Viral Gene Therapy
DNA/RNA delivered via modified virus
✅ Often yes (permanent changes)
Genetic disease correction
🔴 Higher risk (immune activation)
❌ Often blocked by immune memory
Highly regulated globally
In short, plasmid therapy offers a safer, more flexible option for patients who want the benefits of gene therapy without the risks of permanent gene modification.
Effective, Ethical, Safe
GARM Clinic chose plasmid-based delivery because it aligns with our values: effective, ethical, and engineered for safety. This is gene therapy built for responsible adults—not science fiction, and not off-limits to those who want real results now.
Frequently Asked Questions (FAQs)
We've compiled answers to the most common questions about follistatin gene therapy—optimized for clarity, accuracy, and quick understanding. Whether you're curious about cost, legality, safety, or results, you'll find straightforward answers below.
What is follistatin gene therapy?
Follistatin gene therapy is a treatment that uses plasmid-based gene delivery to help your body produce more follistatin—a protein that blocks myostatin and promotes muscle growth, fat loss, and cellular rejuvenation.
How much muscle can I gain from follistatin therapy?
In early clinical studies, participants gained an average of 2–12 pounds of lean muscle over 90 days, depending on age, training habits, and baseline muscle mass.
Does follistatin therapy help with fat loss too?
Yes. Most patients experience improved body composition, including reduced visceral fat and a lower body fat percentage. This is driven by increased muscle mass, improved metabolism, and possible direct effects on fat tissue.
Can follistatin gene therapy reverse aging?
While it doesn’t stop aging, studies show it may reverse biological age markers, including epigenetic clocks and telomere length, especially in older adults. Patients often feel stronger, more energetic, and metabolically younger after treatment.
Is follistatin gene therapy legal?
Yes. Follistatin gene therapy is legally administered at GARM Clinic in Roatán, Honduras under a medical innovation framework. It is not FDA-approved in the U.S. but is offered in compliance with local regulatory standards.
Is this the same as taking a follistatin supplement?
No. Oral supplements claiming to raise follistatin have no reliable clinical evidence behind them. Gene therapy is the only proven method to significantly elevate follistatin levels in the body for extended periods.
How long do the effects of the therapy last?
Most patients experience benefits for 6 to 12 months, depending on individual biology. The therapy can be repeated after this window if desired.
Is the treatment permanent?
No. The plasmid used in this therapy does not alter your DNA. It provides temporary instructions to your cells to produce follistatin, and naturally degrades over time.
Is follistatin gene therapy safe?
Yes. In both published clinical trials and GARM’s own patient outcomes, the therapy has shown a high safety profile with no serious adverse events. Mild side effects (if any) include temporary soreness or fatigue.
Who is a good candidate for this therapy?
Ideal candidates include:
• Adults 35–80 experiencing muscle loss
• Patients with early frailty or sarcopenia
• Bio-optimizers and longevity-focused individuals
• Recreational athletes or those recovering from injury
Can I receive the therapy more than once?
Yes. Because plasmid therapy is non-permanent and non-integrating, it can be safely repeated after the effects wear off—typically after 9 to 12 months.
Will this therapy disqualify me from competitive sports?
Yes. Follistatin gene therapy is banned by WADA and most professional sports organizations. Competitive athletes should not receive this treatment unless they are no longer bound by anti-doping rules.
Is there a set dosage for follistatin therapy?
Yes. GARM uses a precisely measured, single-dose plasmid injection that has been clinically validated for safety and efficacy. The dosage is standardized and not adjusted by weight or gender.
How do I start the process to get treated?
Start by completing a short intake form on the GARM Clinic website. Our care team will guide you through screening, scheduling, and travel logistics from start to finish.
Why Choose GARM Clinic for Follistatin Therapy?
If you’re seeking the most advanced regenerative treatments available today, GARM Clinic stands apart as a global leader in safe, science-backed, and ethically delivered gene therapy. We don’t just offer access to follistatin—we help you unlock its full potential through expert care, world-class oversight, and concierge-level service.
Here’s why patients from around the world choose us:
GARM Clinic is the original clinical provider of Minicircle’s plasmid-based follistatin gene therapy. Our partnership grants patients early access to the most advanced gene delivery technology available anywhere in the world—backed by safety data, published trials, and real-world success.
We don’t offer knockoff peptides or unregulated supplements. This is real gene therapy, delivered legally, responsibly, and with full transparency.
Our treatments are administered by licensed, board-certified physicians who specialize in regenerative, orthopedic, and performance medicine. Every patient is screened, evaluated, and guided by medical professionals—not salespeople or marketers.
That means you’ll receive:
• Clinical-grade care
• Personalized attention
• Evidence-based protocols
You’re not a customer—you’re a patient under our care.
We’ve built our entire program around one principle: do it right, or don’t do it at all.
That’s why we use:
• GMP-compliant therapeutic-grade plasmids
• Extensive pre-screening and medical eligibility checks
• Structured follow-up protocols and biomarker tracking
• Transparent documentation of outcomes and adverse events (which have been minimal to date)
You’ll never be rushed into treatment. You’ll always know what to expect. And you’ll have a team committed to your safety at every step.
From entrepreneurs and executives to elite athletes and retirees, our clientele includes patients from over 30 countries—each seeking the same thing: more life in their years.
GARM Clinic isn’t just a treatment destination—it’s a trusted hub for those pursuing:
• Strength without shortcuts
• Aging without decline
• A smarter way to stay physically, mentally, and metabolically young
We bring together medical science, legal access, and personalized care to deliver world-class results with Caribbean hospitality.



5.avif)
.avif)
.avif)
6.avif)